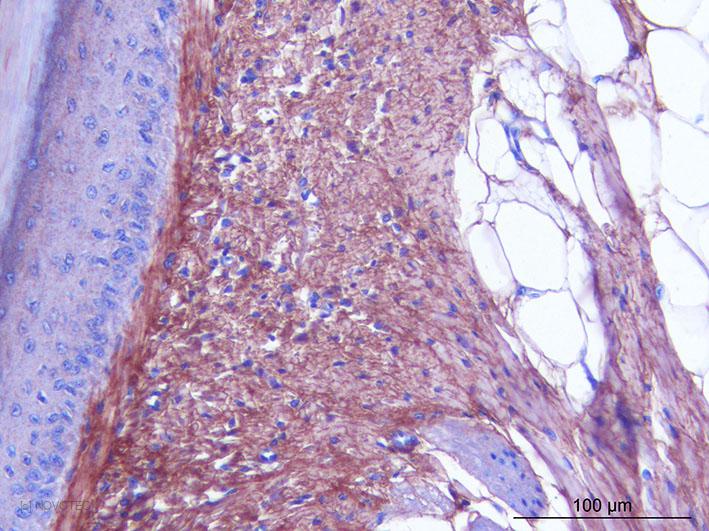

Anticorps > 20131 - Purified freeze-dried antibody to chicken type I collagen
20131 - Purified freeze-dried antibody to chicken type I collagen
Type I collagen is a fibrillar collagen composed of two identical chain α1(I) chains and one α2(I). Type I collagen is found in most connective tissues and is abundant in bone, cornea, dermis and tendon. Mutations in this gene are associated with osteogenesis imperfecta types I-IV, Ehlers-Danlos syndrome type VIIA, Ehlers-Danlos syndrome Classical type, Caffey Disease and idiopathic osteoporosis. [according to R. Dalgleish]
Immunogen : Type I collagen extracted from chicken skin.
Host : Rabbit.
Polyclonal antibody purified by chromatography.
For research only.
Purified, freeze-dried antibody in 0.1 mL vials. Reconstitute with 0.1 mL distilled water and store aliquots at -20°C.
Unreconstituted
24 months at -20°C.
Reconstituted
Before use aliquot and store at -20°C (6 months). Avoid repeated freeze/thaw cycles.
Applications
IF, IHC, ELISA, SP(RIA).
Working dilutions
ELISA ≥ 1/2000 (OD = 0.5)
IF ≥ 1/40
IHC ≥ 1/500
Optimal dilutions should be determined by the end user.
- #492d
-
IgG
2.17 mg/mL
pH
7.44
ELISA
Optimal working dilution at 1/50000.
IF
Optimal working dilution not tested with our current protocol.
IHC
Immunoperoxidase technique with the Envision / Dako kit, 0.5% hyaluronidase pretreatment, optimal working dilution at 1/1000 on fixed paraffin-embedded chicken skin.
-
Presentation
Type I collagen is a fibrillar collagen composed of two identical chain α1(I) chains and one α2(I). Type I collagen is found in most connective tissues and is abundant in bone, cornea, dermis and tendon. Mutations in this gene are associated with osteogenesis imperfecta types I-IV, Ehlers-Danlos syndrome type VIIA, Ehlers-Danlos syndrome Classical type, Caffey Disease and idiopathic osteoporosis. [according to R. Dalgleish]
Description
Immunogen : Type I collagen extracted from chicken skin.
Host : Rabbit.
Polyclonal antibody purified by chromatography.
For research only.
Format
Purified, freeze-dried antibody in 0.1 mL vials. Reconstitute with 0.1 mL distilled water and store aliquots at -20°C.
Stability
Unreconstituted
24 months at -20°C.
Reconstituted
Before use aliquot and store at -20°C (6 months). Avoid repeated freeze/thaw cycles.
Use
Applications
IF, IHC, ELISA, SP(RIA).
Working dilutions
ELISA ≥ 1/2000 (OD = 0.5)
IF ≥ 1/40
IHC ≥ 1/500
Optimal dilutions should be determined by the end user.
Lots
- #492d
-
IgG :
2.17 mg/mL
pH :
7.44
ELISA
Optimal working dilution at 1/50000.
IF
Optimal working dilution not tested with our current protocol.
IHC
Immunoperoxidase technique with the Envision / Dako kit, 0.5% hyaluronidase pretreatment, optimal working dilution at 1/1000 on fixed paraffin-embedded chicken skin.
-
References
- «Electrophoretic and immunochemeical study of collagens from Sepia officinalis cartilage. Biochim. Biophys. Acta 2002, 1572, 77-84.»
Rigo C., Hartmann D.J., Bairati A. - «Immunohistochemical study of collagens of the extracellular matrix in cartilage of Sepia officinalis. Eur. J. Histochem. 1999, 43, 211-225.»
Bairati A., Comazzi M., Gioria M., Hartmann D.J., Leone F., Rigo C. - «Bone organotypic culture method: a model for cytocompatibility testing of biomaterials. Cells and Materials 1994, 4, 113-123.»
Anselme K., Lanel B., Gentil C., Hardouin P., Marie P.J., Sigot-Luizard M.F. - «Four markers of collagen metabolism as possible indicators of disease in the adult respiratory distress syndrome. Am. Rev. Respir. DIs. 1993, 147, 1091-1099.»
Farjanel J., Hartmann D.J., Guidet B., Luquel L., Offenstadt G. - «Expression of Type X collagen is transiently stimulated in redifferentiating chondrocytes pretreated with retinoic acid. Biochem. J. 1991, 276, 183-187.»
Sanchez M., Gionti E., Pontarelli G., Arcella A., De Lorenzo F. - «Proteglycan and collagen synthesis are correlated with actin organization in dedifferentiating chondrocytes. Eur. J. Cell. Biol. 1991, 56, 364-373.»
Mallein-Gerin F., Garrone R., Van der Rest M. - «Structural and compositional divergencies in the extracellular matrix encountered by neural crest cells in the white mutant axolotl embryo. Development 1990, 109, 533-551.»
Perris R., Löfberg J., Fällström C., Von Boxberg Y., Olsson L., Newgreen D.F. - «Proteoglycan core protein and type II collagen gene expressions are not correlated with cell shape changes during low density chondrocyte cultures. Differentiation 1990, 43, 204-211.»
Mallein-Gerin F., Ruggiero F., Garrone R. - «Production of fibronectin and collagen types I and III by chick embryo dermal cells cultured on extracellular matrix substrates. Int. J. Dev. Biol. 1989, 33, 267-275.»
Robert J., Hartmann D.J., Sengel P. - «Influence of various extracellular matrix components on the behavior of cultured chick embryo dermal cells. Int. J. Dev. Biol. 1989, 33, 227-237.»
Robert J., Mauger A., Sengel P. - «In vitro morphogenesis of chick embryo hypertrophic cartilage. J. Cell. Biol., 1987, 105, 999-1006.»
Tacchetti C., Quarto R., Nitsch L., Hartmann D.J., Cancedda R. - «Distribution of laminin and collagens during avian neural crest development. Development 1987, 101, 461-478.»
Duband J.L., Thiery J.P. - «Immunofluorescent localization of collagen types I, III, IV, fibronectin and laminin during morphogenesis of scales and scaleless skin in the chick embryo. Roux's Arch. Dev. Biol. 1983, 192, 205-215.»
Mauger A., Demarchez M., Herbage D., Grimaud J.A., Druguet M., Hartmann D.J. Foidart J.M., Sengel P. - «Immunofluorescent localization of collagen types I and III, and of fibronectin during feather morphogenesis in the chick embryo. Dev. Biol. 1982, 94, 93-105.»
Mauger A., Demarchez M., Herbage D., Grimaud J.A., Druguet M., Hartmann D., Sengel P. - «Répartition du collagène, de la fibronectine et de la laminine au cours de la morphogénèse de la peau et des phanères chez l'embryon de poulet. C. R. Acad. Sc. Paris 1982, 294, 475-480.»
Mauger A., Demarchez M., Georges D., Herbage D., Grimaud J.A., Druguet M., Hartmann D.J., Sengel P.